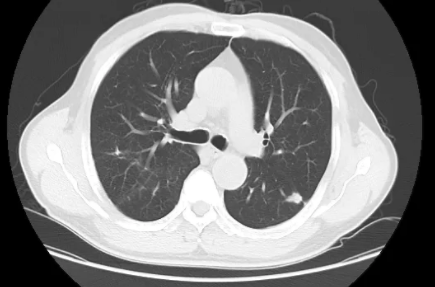
肺部ct有结节

现在为什么查出有肺结节的人越来越多呢?
首先,人们健康意识提高,体检发现肺部ct有结节的多了,并不是原来没有。其次,人民平均寿命的延长,伴有而来的健康问题自然增多。最关键的是,因为ct在临床诊疗、健康体检和疾病筛查中的普遍应用,ct具有普通x线无法比拟的优势,分辨力高、可以避免肋骨、脊柱、心脏的阻挡而清晰的观察肺组织,直径≤1.0cm甚至<0.5cm的小结节现在也很容易被观察到。
当然,肺结节跟吸烟、二手烟也有一定关系。再加上现在人的生活压力大、生闷气、熬夜、焦虑等因素。虽然环境对我们也有影响,但是不会有我们想象的那么严重。
肺部结节一般会有什么症状呢?
肺部小结节的直径小于2厘米的,一般不会引起患者的症状。有些患者发现肺部小结节后,出现咳嗽、咳痰,甚至有胸闷、气短等症状,认为是肺部小结节引起的,担心是病情进展。其实,这是一个误区,因为只有支气管受到影响才会引起咳嗽、咳痰等症状,而肺部小结节的体积小,一般不会影响到支气管。因此,出现咳嗽、咳痰等症状一般与肺部小结节无关。
肺结节的临床分类:
分类的原因是其大小、密度、形态等与结节的良、恶性具有一定程度相关性。通常大于20mm的病灶恶性比例较高,而小结节则良性的概率更大。
(一)按照病灶大小分类:
1.肺内生长类圆形、边界清楚、直径大于30mm的病灶称为肺部肿块;
2.肺内生长类圆形、边界清楚、直径小于30mm的病灶称为肺部结节;
3.肺内生长类圆形、边界清楚、直径小于20mm的病灶称为肺部小结节,小于5mm的结节称为肺部微小结节。
(二)按照密度分类:
分为实性结节和亚实性结节,亚实性结节包含:纯磨玻璃结节和混合磨玻璃结节。
(三)按照数量分类:
分为孤立性(单个结节)和多发性(2个及以上)